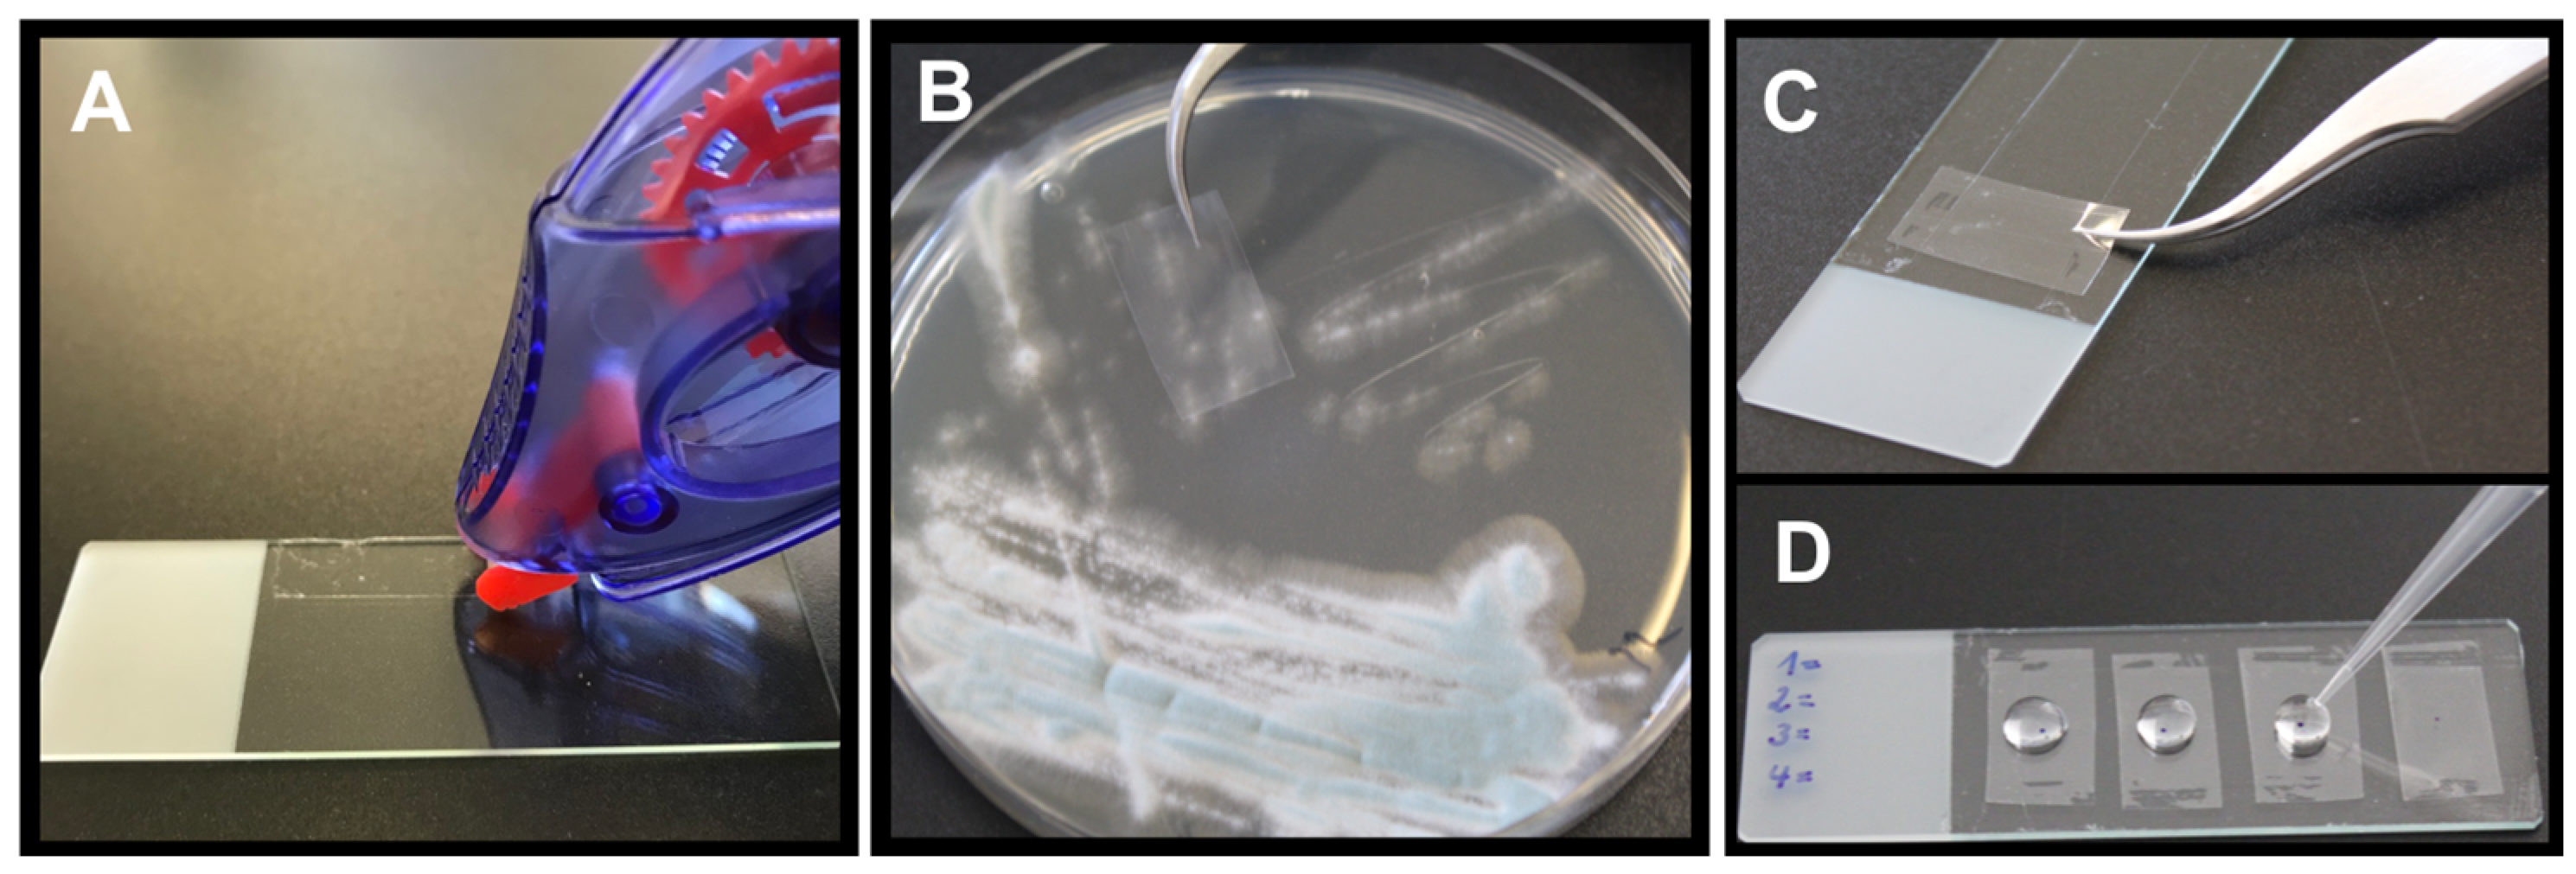
Jof 09 00622 g001 Jof 09 00622 g001

The Novel Monoclonal IgG1-Antibody AB90-E8 as a Diagnostic Tool to Rapidly Distinguish Aspergillus fumigatus from Other Human Pathogenic Aspergillus Species
Abstract
1. Introduction
2. Materials and Methods
2.1. Strains and Media
2.2. Antibodies for Immunostaining
2.3. Staining of Hyphae Grown on Glass Cover Slips
2.3.1. Growth in Liquid Culture and Immunostaining
2.3.2. Fludioxonil Treatment
2.3.3. Growth and Infection of A549 Epithelial Cells
2.4. Direct Staining of Hyphae from Agar Plates
2.4.1. Picking Method
2.4.2. Tape Mount Immunostaining Method
2.5. Staining of Histological Samples
2.6. Microscopy
3. Results
3.1. Characterization of the Monoclonal Antibody AB90-E8
3.2. Application of AB90-E8 as a Diagnostic Tool
3.2.1. Direct Staining of Hyphae from Agar Plates—Picking Method
3.2.2. Direct Staining of Hyphae from Agar Plates—Tape Mount Immunostaining Method
3.2.3. Staining of Histological Samples
4. Discussion
Author Contributions
Funding
Institutional Review Board Statement
Informed Consent Statement
Data Availability Statement
Acknowledgments
Conflicts of Interest
References
- Kousha, M.; Tadi, R.; Soubani, A. Pulmonary aspergillosis: A clinical review. Eur. Respir. Rev. 2011, 20, 156–174. [Google Scholar] [CrossRef] [PubMed]
- Donnelly, J.P.; Chen, S.C.; Kauffman, C.A.; Steinbach, W.J.; Baddley, J.W.; Verweij, P.E.; Clancy, C.J.; Wingard, J.R.; Lockhart, S.R.; Groll, A.H.; et al. Revision and Update of the Consensus Definitions of Invasive Fungal Disease From the European Organization for Research and Treatment of Cancer and the Mycoses Study Group Education and Research Consortium. Clin. Infect. Dis. 2020, 71, 1367–1376. [Google Scholar] [CrossRef] [PubMed]
- Lamoth, F. Invasive aspergillosis in coronavirus disease 2019: A practical approach for clinicians. Curr. Opin. Infect. Dis. 2022, 35, 163–169. [Google Scholar] [CrossRef] [PubMed]
- Bassetti, M.; Peghin, M.; Vena, A. Challenges and Solution of Invasive Aspergillosis in Non-neutropenic Patients: A Review. Infect. Dis. Ther. 2017, 7, 17–27. [Google Scholar] [CrossRef] [PubMed]
- Trof, R.J.; Beishuizen, A.; Debets-Ossenkopp, Y.J.; Girbes, A.R.J.; Groeneveld, A.B.J. Management of invasive pulmonary aspergillosis in non-neutropenic critically ill patients. Intensiv. Care Med. 2007, 33, 1694–1703. [Google Scholar] [CrossRef]
- Cornillet, A.; Camus, C.; Nimubona, S.; Gandemer, V.; Tattevin, P.; Belleguic, C.; Gangneux, J.P. Comparison of epidemiological, clinical, and biological features of invasive aspergillosis in neutropenic and nonneutropenic patients: A 6-year survey. Clin. Infect. Dis. 2006, 43, 577–584. [Google Scholar] [CrossRef]
- Neofytos, D.; Treadway, S.; Ostrander, D.; Alonso, C.; Dierberg, K.; Nussenblatt, V.; Durand, C.; Thompson, C.; Marr, K. Epidemiology, outcomes, and mortality predictors of invasive mold infections among transplant recipients: A 10-year, single-center experience. Transpl. Infect. Dis. 2013, 15, 233–242. [Google Scholar] [CrossRef]
- Pappas, P.G.; Alexander, B.D.; Andes, D.R.; Hadley, S.; Kauffman, C.A.; Freifeld, A.; Chiller, T.M. Invasive fungal infections among organ transplant recipients: Results of the Transplant-Associated Infection Surveillance Network (TRANSNET). Clin. Infect. Dis. 2010, 50, 1101–1111. [Google Scholar] [CrossRef]
- Henriet, S.S.V.; Verweij, P.E.; Warris, A. Aspergillus nidulans and Chronic Granulomatous Disease: A Unique Host–Pathogen Interaction. J. Infect. Dis. 2012, 206, 1128–1137. [Google Scholar] [CrossRef]
- Risslegger, B.; Zoran, T.; Lackner, M.; Aigner, M.; Sánchez-Reus, F.; Rezusta, A.; Chowdhary, A.; Taj-Aldeen, S.J.; Arendrup, M.C.; Oliveri, S.; et al. A prospective international Aspergillus terreus survey: An EFISG, ISHAM and ECMM joint study. Clin. Microbiol. Infect. 2017, 23, 776.e1–776.e5. [Google Scholar] [CrossRef]
- Walsh, T.J.; Petraitis, V.; Petraitiene, R.; Field-Ridley, A.; Sutton, D.; Ghannoum, M.; Sein, T.; Schaufele, R.; Peter, J.; Bacher, J.; et al. Experimental Pulmonary Aspergillosis Due to Aspergillus terreus: Pathogenesis and Treatment of an Emerging Fungal Pathogen Resistant to Amphotericin B. J. Infect. Dis. 2003, 188, 305–319. [Google Scholar] [CrossRef] [PubMed]
- Lass-Flörl, C.; Dietl, A.M.; Kontoyiannis, D.P.; Brock, M. Aspergillus terreus species complex. Clin. Microbiol. Rev. 2021, 34, e00311-20. [Google Scholar] [CrossRef] [PubMed]
- Lass-Florl, C.; Grif, K.; Kontoyiannis, D.P. Molecular typing of Aspergillus terreus isolates collected in Houston, Texas, and Innsbruck, Austria: Evidence of great genetic diversity. J. Clin. Microbiol. 2007, 45, 2686–2690. [Google Scholar] [CrossRef]
- Dietl, A.M.; Vahedi-Shahandashti, R.; Kandelbauer, C.; Kraak, B.; Lackner, M.; Houbraken, J.; Lass-Flörl, C. The environmental spread of Aspergillus terreus in Tyrol, Austria. Microorganisms 2021, 9, 539. [Google Scholar] [CrossRef] [PubMed]
- Ruhnke, M.; Cornely, O.A.; Schmidt-Hieber, M.; Alakel, N.; Boell, B.; Buchheidt, D.; Christopeit, M.; Hasenkamp, J.; Heinz, W.J.; Hentrich, M.; et al. Treatment of invasive fungal diseases in cancer patients—Revised 2019 Recommendations of the Infectious Diseases Working Party (AGIHO) of the German Society of Hematology and Oncology (DGHO). Mycoses 2020, 63, 653–682. [Google Scholar] [CrossRef]
- Van Der Linden, J.W.; Warris, A.; Verweij, P.E. Aspergillus species intrinsically resistant to antifungal agents. Med. Mycol. 2011, 49 (Suppl. S1), S82–S89. [Google Scholar] [CrossRef]
- Slesiona, S.; Ibrahim-Granet, O.; Olias, P.; Brock, M.; Jacobsen, I.D. Murine Infection Models for Aspergillus terreus Pulmonary Aspergillosis Reveal Long-term Persistence of Conidia and Liver Degeneration. J. Infect. Dis. 2012, 205, 1268–1277. [Google Scholar] [CrossRef]
- Papon, N.; Courdavault, V.; Lanoue, A.; Clastre, M.; Brock, M. Illuminating Fungal Infections with Bioluminescence. PLOS Pathog. 2014, 10, e1004179. [Google Scholar] [CrossRef]
- Slesiona, S.; Gressler, M.; Mihlan, M.; Zaehle, C.; Schaller, M.; Barz, D.; Hube, B.; Jacobsen, I.D.; Brock, M. Persistence versus Escape: Aspergillus terreus and Aspergillus fumigatus Employ Different Strategies during Interactions with Macrophages. PLoS ONE 2012, 7, e31223. [Google Scholar] [CrossRef]
- Hsieh, S.-H.; Kurzai, O.; Brock, M. Persistence within dendritic cells marks an antifungal evasion and dissemination strategy of Aspergillus terreus. Sci. Rep. 2017, 7, 10590. [Google Scholar] [CrossRef]
- Deak, E.; Wilson, S.D.; White, E.; Carr, J.H.; Balajee, S.A. Aspergillus terreus Accessory Conidia Are Unique in Surface Architecture, Cell Wall Composition and Germination Kinetics. PLoS ONE 2009, 4, e7673. [Google Scholar] [CrossRef]
- Henß, I.; Kleinemeier, C.; Strobel, L.; Brock, M.; Löffler, J.; Ebel, F. Characterization of Aspergillus terreus Accessory Conidia and Their Interactions With Murine Macrophages. Front. Microbiol. 2022, 13, 896145. [Google Scholar] [CrossRef]
- Batchelor, R.; Thomas, C.; Gardiner, B.J.; Lee, S.J.; Fleming, S.; Wei, A.; Coutsouvelis, J.; Ananda-Rajah, M. When Azoles Cannot Be Used: The Clinical Effectiveness of Intermittent Liposomal Amphotericin Prophylaxis in Hematology Patients. Open Forum Infect. Dis. 2021, 8, ofab113. [Google Scholar] [CrossRef]
- Seif, M.; Kakoschke, T.K.; Ebel, F.; Bellet, M.M.; Trinks, N.; Renga, G.; Löffler, J. CAR T cells targeting Aspergillus fumigatus are effective at treating invasive pulmonary aspergillosis in preclinical models. Sci. Transl. Med. 2022, 14, eabh1209. [Google Scholar] [CrossRef] [PubMed]
- Hearn, V.M.; MacKenzie, D.W. Mycelial antigens from two strains of Aspergillus fumigatus: An analysis by two-dimensional immunoelectrophoresis. Mykosen 1980, 23, 549–562. [Google Scholar] [CrossRef] [PubMed]
- d’Enfert, C. Selection of multiple disruption events in Aspergillus fumigatus using the orotidine-5′-decarboxylase gene, pyrG, as a unique transformation marker. Curr. Genet. 1996, 30, 76–82. [Google Scholar] [CrossRef] [PubMed]
- Pain, A.; Woodward, J.; Quail, M.; Anderson, M.J.; Clark, R.; Collins, M.; Fosker, N.; Fraser, A.; Harris, D.; Larke, N.; et al. Insight into the genome of Aspergillus fumigatus: Analysis of a 922kb region encompassing the nitrate assimilation gene cluster. Fungal Genet. Biol. 2004, 41, 443–453. [Google Scholar] [CrossRef] [PubMed]
- Nierman, W.C.; Pain, A.; Anderson, M.J.; Wortman, J.R.; Kim, H.S.; Arroyo, J.; Denning, D.W. Genomic sequence of the pathogenic and allergenic filamentous fungus Aspergillus fumigatus. Nature 2005, 438, 1151–1156. [Google Scholar] [CrossRef] [PubMed]
- Staib, F.; Mishra, S.K.; Rajendran, C.; Voigt, R.; Steffen, J.; Neumann, K.H.; Hartmann, C.; Heins, G. A notable Aspergillus from a mortal aspergilloma of the lung. New aspects of the epidemiology, serodiagnosis and taxonomy of Aspergillus fumigatus. Zent. Bakteriol A 1980, 247, 530–536. [Google Scholar] [CrossRef]
- Wagener, J.; Echtenacher, B.; Rohde, M.; Kotz, A.; Krappmann, S.; Heesemann, J.; Ebel, F. The Putative α-1,2-Mannosyltransferase AfMnt1 of the Opportunistic Fungal Pathogen Aspergillus fumigatus Is Required for Cell Wall Stability and Full Virulence. Eukaryot. Cell 2008, 7, 1661–1673. [Google Scholar] [CrossRef] [PubMed]
- Meier, A.; Kirschning, C.J.; Nikolaus, T.; Wagner, H.; Heesemann, J.; Ebel, F. Toll-like receptor (TLR) 2 and TLR4 are essential for Aspergillus-induced activation of murine macrophages. Cell. Microbiol. 2003, 5, 561–570. [Google Scholar] [CrossRef] [PubMed]
- Schmalhorst, P.S.; Krappmann, S.; Vervecken, W.; Rohde, M.; Muller, M.; Braus, G.H.; Contreras, R.; Braun, A.; Bakker, H.; Routier, F.H. Contribution of Galactofuranose to the Virulence of the Opportunistic Pathogen Aspergillus fumigatus. Eukaryot. Cell 2008, 7, 1268–1277. [Google Scholar] [CrossRef]
- Raper, K.B.; Fennell, D.I. The Genus Aspergillus; Williams and Wilkins: Baltimore, MD, USA, 1965. [Google Scholar]
- Jukic, E.; Blatzer, M.; Binder, U.; Mayr, L.; Lass-Flörl, C.; Lackner, M. Impact of Morphological Sectors on Antifungal Susceptibility Testing and Virulence Studies. Antimicrob. Agents Chemother. 2017, 61, e00755-17. [Google Scholar] [CrossRef]
- Behal, F.J.; Eakin, R.E. Inhibition of mold development by purine and pyrimidine analogs. Arch. Biochem. Biophys. 1959, 82, 439–447. [Google Scholar] [CrossRef]
- Ray, A.C.; Eakin, R. Studies on the biosynthesis of aspergillin by Aspergillus niger. Appl. Environ. Microbiol. 1975, 30, 909–915. [Google Scholar] [CrossRef]
- Pel, H.J.; de Winde, J.H.; Archer, D.B.; Dyer, P.S.; Hofmann, G.; Schaap, P.J.; Turner, G.; de Vries, R.P.; Albang, R.; Albermann, K.; et al. Genome sequencing and analysis of the versatile cell factory Aspergillus niger CBS 513.88. Nat. Biotechnol. 2007, 25, 221–231. [Google Scholar] [CrossRef]
- Heesemann, L.; Kotz, A.; Echtenacher, B.; Broniszewska, M.; Routier, F.; Hoffmann, P.; Ebel, F. Studies on galactofuranose-containing glycostructures of the pathogenic mold Aspergillus fumigatus. Int. J. Med. Microbiol. 2011, 301, 523–530. [Google Scholar] [CrossRef] [PubMed]
- Kakoschke, T.K.; Kleinemeier, C.; Langenmayer, M.C.; Ebel, F. Tape mount immunostaining: A versatile method for immunofluorescence analysis of fungi. Futur. Microbiol. 2019, 14, 275–282. [Google Scholar] [CrossRef]
- Wiedemann, A.; Spadinger, A.; Löwe, A.; Seeger, A.; Ebel, F. Agents that activate the High Osmolarity Glycerol pathway as a means to combat pathogenic molds. Int. J. Med. Microbiol. 2016, 306, 642–651. [Google Scholar] [CrossRef] [PubMed]
- Ullmann, A.J.; Aguado, J.M.; Arikan-Akdagli, S.; Denning, D.W.; Groll, A.H.; Lagrou, K.; Lass-Flörl, C.; Lewis, R.E.; Munoz, P.; Verweij, P.E.; et al. Diagnosis and management of Aspergillus diseases: Executive summary of the 2017 ESCMID-ECMM-ERS guideline. Clin. Microbiol. Infect. 2018, 24 (Suppl. S1), e1–e38. [Google Scholar] [CrossRef]
- Monheit, J.; Cowan, D.F.; Moore, D.G. Rapid detection of fungi in tissues using calcofluor white and fluorescence microscopy. Arch. Pathol. Lab. Med. 1984, 108, 616–618. [Google Scholar]
- Rüchel, R.; Schaffrinski, M. Versatile fluorescent staining of fungi in clinical specimens by using the optical brightener Blankophor. J. Clin. Microbiol. 1999, 37, 2694–2696. [Google Scholar] [CrossRef] [PubMed]
- Hamer, E.; Moore, C.; Denning, D. Comparison of two fluorescent whiteners, Calcofluor and Blankophor, for the detection of fungal elements in clinical specimens in the diagnostic laboratory. Clin. Microbiol. Infect. 2006, 12, 181–184. [Google Scholar] [CrossRef] [PubMed]
- Zhang, J.; Debets, A.J.M.; Verweij, P.E.; Schoustra, S.E. Selective Flamingo Medium for the Isolation of Aspergillus fumigatus. Microorganisms 2021, 9, 1155. [Google Scholar] [CrossRef]
- Jensen, H.E.; Aalbaek, B.; Lind, P.; Krogh, H.V.; Frandsen, P.L. Development of Murine Monoclonal Antibodies for the Immunohistochemical Diagnosis of Systemic Bovine Aspergillosis. J. Vet.-Diagn. Investig. 1996, 8, 68–75. [Google Scholar] [CrossRef] [PubMed]
- Choi, J.K.; Mauger, J.; McGowan, K.L. Immunohistochemical detection of Aspergillus species in pediatric tissue samples. Am. J. Clin. Pathol. 2004, 121, 18–25. [Google Scholar] [CrossRef]
- Stynen, D.; Sarfati, J.; Goris, A.; Prévost, M.C.; Lesourd, M.; Kamphuis, H.; Darras, V.; Latgé, J.P. Rat monoclonal antibodies against Aspergillus galactomannan. Infect. Immun. 1992, 60, 2237–2245. [Google Scholar] [CrossRef] [PubMed]
- Torosantucci, A.; Chiani, P.; Bromuro, C.; De Bernardis, F.; Palma, A.S.; Liu, Y.; Cassone, A. Protection by anti-β-glucan antibodies is associated with restricted β-1, 3 glucan binding specificity and inhibition of fungal growth and adherence. PLoS ONE 2009, 4, e5392. [Google Scholar] [CrossRef] [PubMed]
- Thornton, C.R. Development of an Immunochromatographic Lateral-Flow Device for Rapid Serodiagnosis of Invasive Aspergillosis. Clin. Vaccine Immunol. 2008, 15, 1095–1105. [Google Scholar] [CrossRef]
- Wiederhold, N.P.; Najvar, L.K.; Bocanegra, R.; Kirkpatrick, W.R.; Patterson, T.F.; Thornton, C.R. Interlaboratory and Interstudy Reproducibility of a Novel Lateral-Flow Device and Influence of Antifungal Therapy on Detection of Invasive Pulmonary Aspergillosis. J. Clin. Microbiol. 2013, 51, 459–465. [Google Scholar] [CrossRef]
- Dichtl, K.; Seybold, U.; Ormanns, S.; Horns, H.; Wagener, J. Evaluation of a Novel Aspergillus Antigen Enzyme-Linked Immunosorbent Assay. J. Clin. Microbiol. 2019, 57, e00136-19. [Google Scholar] [CrossRef] [PubMed]
- Steinberg, G.; Penalva, M.; Riquelme, M.; Wösten, H.A.; Harris, S.D. Cell Biology of Hyphal Growth. Microbiol. Spectr. 2017, 5, 231–265. [Google Scholar] [CrossRef] [PubMed]
- Patel, R. A moldy application of MALDI: MALDI-ToF mass spectrometry for fungal identification. J. Fungi 2019, 5, 4. [Google Scholar] [CrossRef] [PubMed]
- Gautier, M.; Ranque, S.; Normand, A.-C.; Becker, P.; Packeu, A.; Cassagne, C.; L’Ollivier, C.; Hendrickx, M.; Piarroux, R. Matrix-assisted laser desorption ionization time-of-flight mass spectrometry: Revolutionizing clinical laboratory diagnosis of mould infections. Clin. Microbiol. Infect. 2014, 20, 1366–1371. [Google Scholar] [CrossRef] [PubMed]
- Vidal-Acuña, M.R.; Ruiz-Pérez de Pipaón, M.; Torres-Sánchez, M.J.; Aznar, J. Identification of clinical isolates of Aspergillus, including cryptic species, by matrix assisted laser desorption ionization time-of-flight mass spectrometry (MALDI-TOF MS). Med. Mycol. 2018, 56, 838–846. [Google Scholar] [CrossRef] [PubMed]
- Imbert, S.; Normand, A.C.; Gabriel, F.; Cassaing, S.; Bonnal, C.; Costa, D.; Lachaud, L.; Hasseine, L.; Kristensen, L.; Schuttler, C.; et al. Multi-centric evaluation of the online MSI platform for the identification of cryptic and rare species of Aspergillus by MALDI-TOF. Med. Mycol. 2019, 57, 962–968. [Google Scholar] [CrossRef]
- Ruhnke, M.; Behre, G.; Buchheidt, D.; Christopeit, M.; Hamprecht, A.; Heinz, W.; Heussel, C.-P.; Horger, M.; Kurzai, O.; Karthaus, M.; et al. Diagnosis of invasive fungal diseases in haematology and oncology: 2018 update of the recommendations of the infectious diseases working party of the German society for hematology and medical oncology (AGIHO). Mycoses 2018, 61, 796–813. [Google Scholar] [CrossRef]

Disclaimer/Publisher’s Note: The statements, opinions and data contained in all publications are solely those of the individual author(s) and contributor(s) and not of MDPI and/or the editor(s). MDPI and/or the editor(s) disclaim responsibility for any injury to people or property resulting from any ideas, methods, instructions or products referred to in the content. |
© 2023 by the authors. Licensee MDPI, Basel, Switzerland. This article is an open access article distributed under the terms and conditions of the Creative Commons Attribution (CC BY) license (https://creativecommons.org/licenses/by/4.0/).
Share and Cite
Kakoschke, T.K.; Kleinemeier, C.; Knösel, T.; Kakoschke, S.C.; Ebel, F. The Novel Monoclonal IgG1-Antibody AB90-E8 as a Diagnostic Tool to Rapidly Distinguish Aspergillus fumigatus from Other Human Pathogenic Aspergillus Species. J. Fungi 2023, 9, 622. https://doi.org/10.3390/jof9060622
Kakoschke TK, Kleinemeier C, Knösel T, Kakoschke SC, Ebel F. The Novel Monoclonal IgG1-Antibody AB90-E8 as a Diagnostic Tool to Rapidly Distinguish Aspergillus fumigatus from Other Human Pathogenic Aspergillus Species. Journal of Fungi. 2023; 9(6):622. https://doi.org/10.3390/jof9060622
Chicago/Turabian StyleKakoschke, Tamara Katharina, Christoph Kleinemeier, Thomas Knösel, Sara Carina Kakoschke, and Frank Ebel. 2023. "The Novel Monoclonal IgG1-Antibody AB90-E8 as a Diagnostic Tool to Rapidly Distinguish Aspergillus fumigatus from Other Human Pathogenic Aspergillus Species" Journal of Fungi 9, no. 6: 622. https://doi.org/10.3390/jof9060622
APA StyleKakoschke, T. K., Kleinemeier, C., Knösel, T., Kakoschke, S. C., & Ebel, F. (2023). The Novel Monoclonal IgG1-Antibody AB90-E8 as a Diagnostic Tool to Rapidly Distinguish Aspergillus fumigatus from Other Human Pathogenic Aspergillus Species. Journal of Fungi, 9(6), 622. https://doi.org/10.3390/jof9060622

